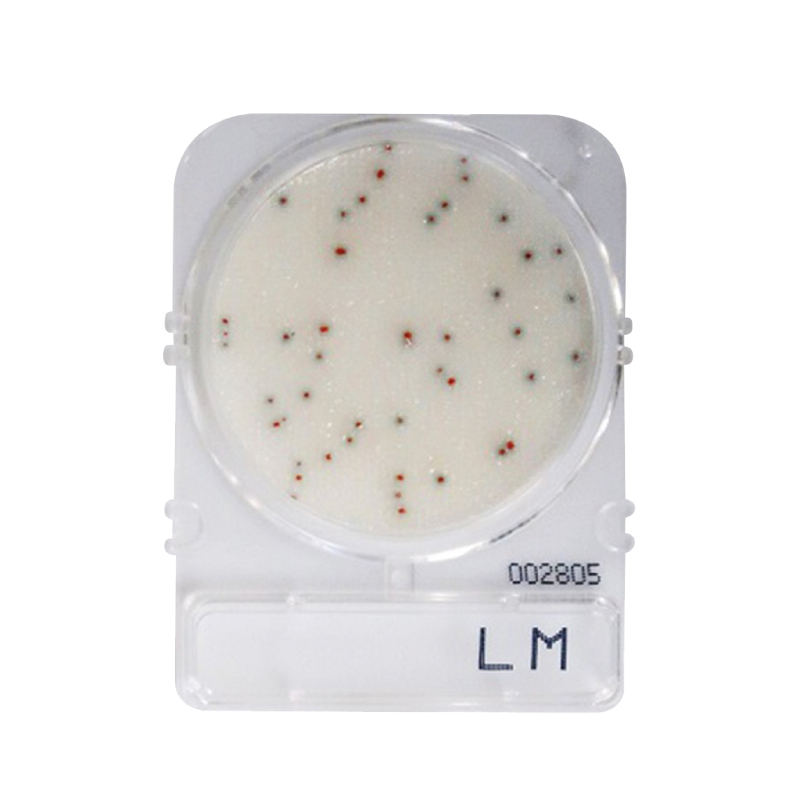
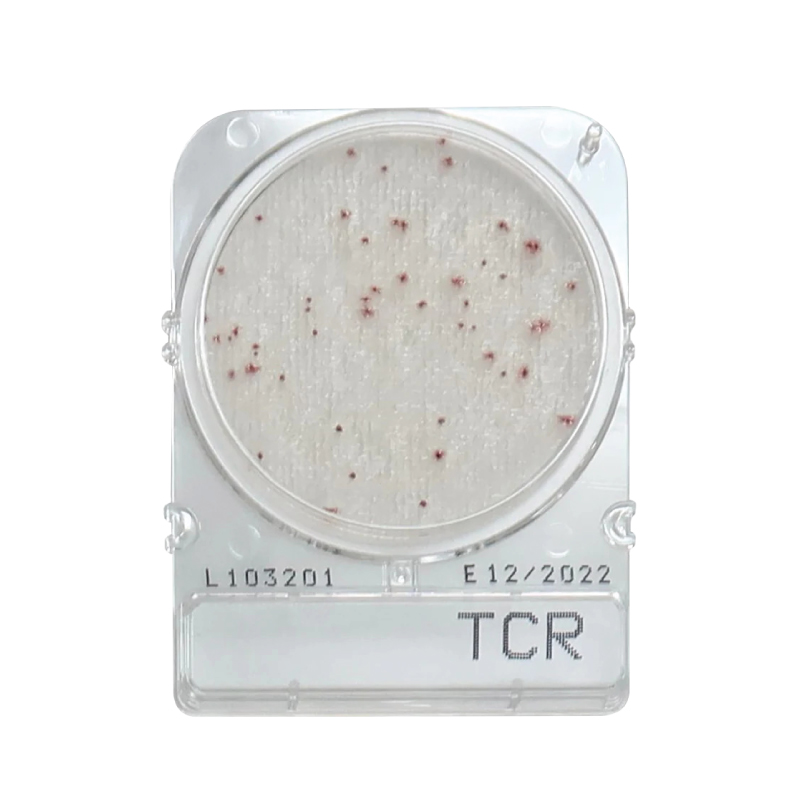

Rastreamento de Cargas
(*) Quando o remetente ou o destinatario for pessoa fisica, adicionar "000" (3 zeros) antes do numero do CPF.

(*) Quando o remetente ou o destinatario for pessoa fisica, adicionar "000" (3 zeros) antes do numero do CPF.